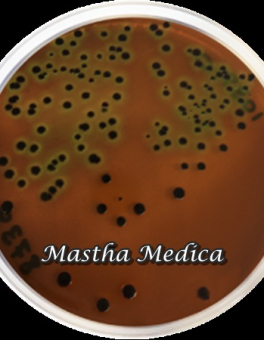

● online
- Alat Bantu Pernafasan Uap Nebulizer Air Compressor....
- Live Dealer Blackjack Kasino Bagaimana Memenangkan....
- Android Kasino Slot Berjudi....
- Jual Blood Lancet Gea / Jarum Lancet / Jarum Bekam....
- Situs Terbaik Kasino Online Tanpa Bonus Deposit....
- Kasino Mesin Spin Langsung 2025....
- Tip Dan Bonus Berputar Kasino Seluler....
- Mesin Slot Baru Dengan Kasino Uang Nyata 2025....
NB : UNTUK PENGIRIMAN WAJIB MENGGUNAKAN EKSPEDISI JNE YES IK Media Tumbuh Agar Garam Manitol Alat Lab Manitol Salt Agar 1 Pack Manitol salt agar merupakan salah satu media pertumbuhan selektif dan diferensial yang umum digunakan dalam mikrobiologi. manitol salt agar ini sebagai salah satu metode membedakan mikroba patogen dalam waktu singkat. Ini mengandung… selengkapnya
Rp 800.000 Rp 945.000Ik NB : PENGIRIMAN HANYA BISA MENGGUNAKAN JNE YES Plate Media Eosin Methylene Blue Agar Alat Lab 1 Pack eosin methylene blue merupakan media selektif dan media diferensial, media ini selektif untuk menumbuhkan bakteri gram negatif dan pada umumnya digunakan untuk isolasi dan diferensiasi bakteri non fecal coliform dan fecal coliform. Spesifikasi :… selengkapnya
Rp 800.000 Rp 1.115.000